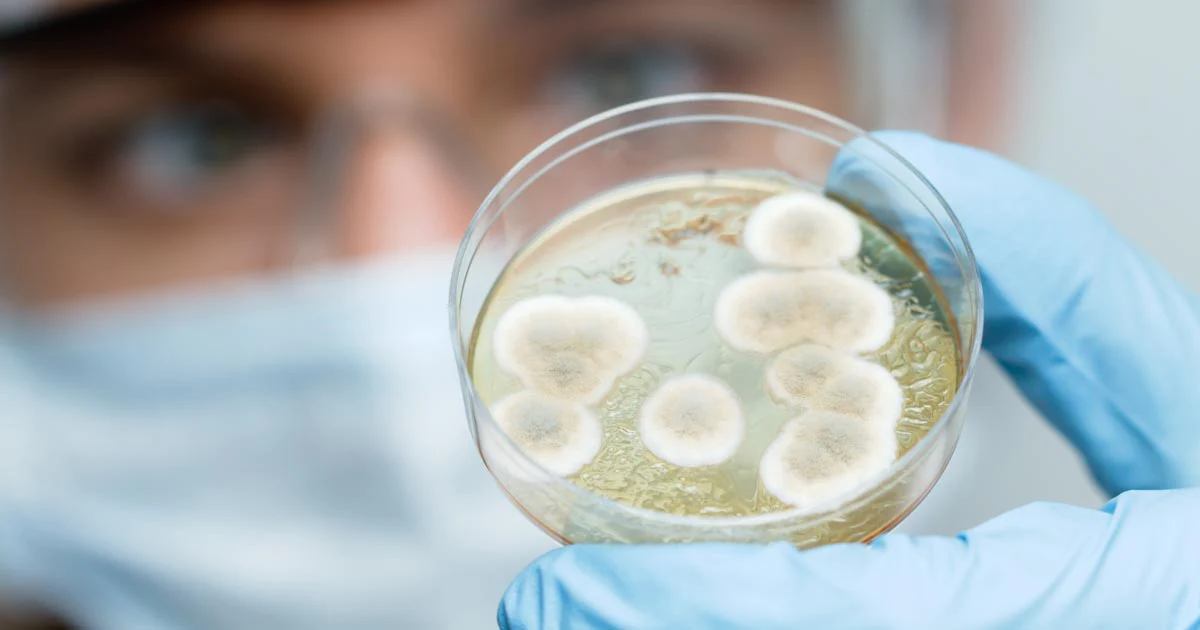

Corporate Video
- Hits: 466
Good indoor air quality and hygiene surface is paramount in medical care facilities including hospitals, healthcare centers, nursing homes, assisted living, clinics and hospice care.
Hospitals are always at risk because they are populated by people with infectious diseases. Medical staff who are in direct contact with patients have a higher risk of exposure to occupational diseases. Visitors, on the other hand are exposed to the risk of transmission of infectious diseases.

The common source of contaminants in multi-specialist care hospitals include:

EcoDifesa provides an acceptable norm (EU, NIOSH) in indoor climate by eliminating odor and airborne contaminants to ensure the health and safety of patients and medical staff


● ICU/ICCU ● OTs ● Burns Unit ● Neonatal ● Ambulances ● Isolation Areas ● Nursing Homes ● IVF Clinics ● Dental Clinics ● Blood Banks ● Laboratories

Antibacteria Hand Sanitizers

Disinfectant Spray

.


Application:
EcoDifesa applied on office furniture’s, glass panels, carpets, floors, walls, ceilings, and computers
Results:
Application:
EcoDifesa applied to all the walls, ceilings, tables, chairs, shelves, cupboards kitchen and washrooms
Results:




Application:
EcoDifesa applied in dental clinic in Sunway, Subang
Result:
Private Cars
Application:
Interior of the car was treated by EcoDifesa
Results:




Application:
Interior and exterior of the car was treated by EcoDifesa
Result:
Application:
Interior of the plane was treated by EcoDifesa
Results:




Application:
Interior of the 2-car train was treated by EcoDifesa
Results:
Application:
EcoDifesa applied on all hotel rooms including toilets, sinks, walls, ceiling, floors, doors, beds, chairs, curtains etc.
Results:






Private/Public Gymnasium
Application:
EcoDifesa applied on gymnasium machines, carpeted floor, walls and ceiling.
Result:
Application:
EcoDifesa applied at management office, ENT, Pathology, Haemodialysis, Chest Clinic, X-Ray Department Patients Waiting area, etc
Results

